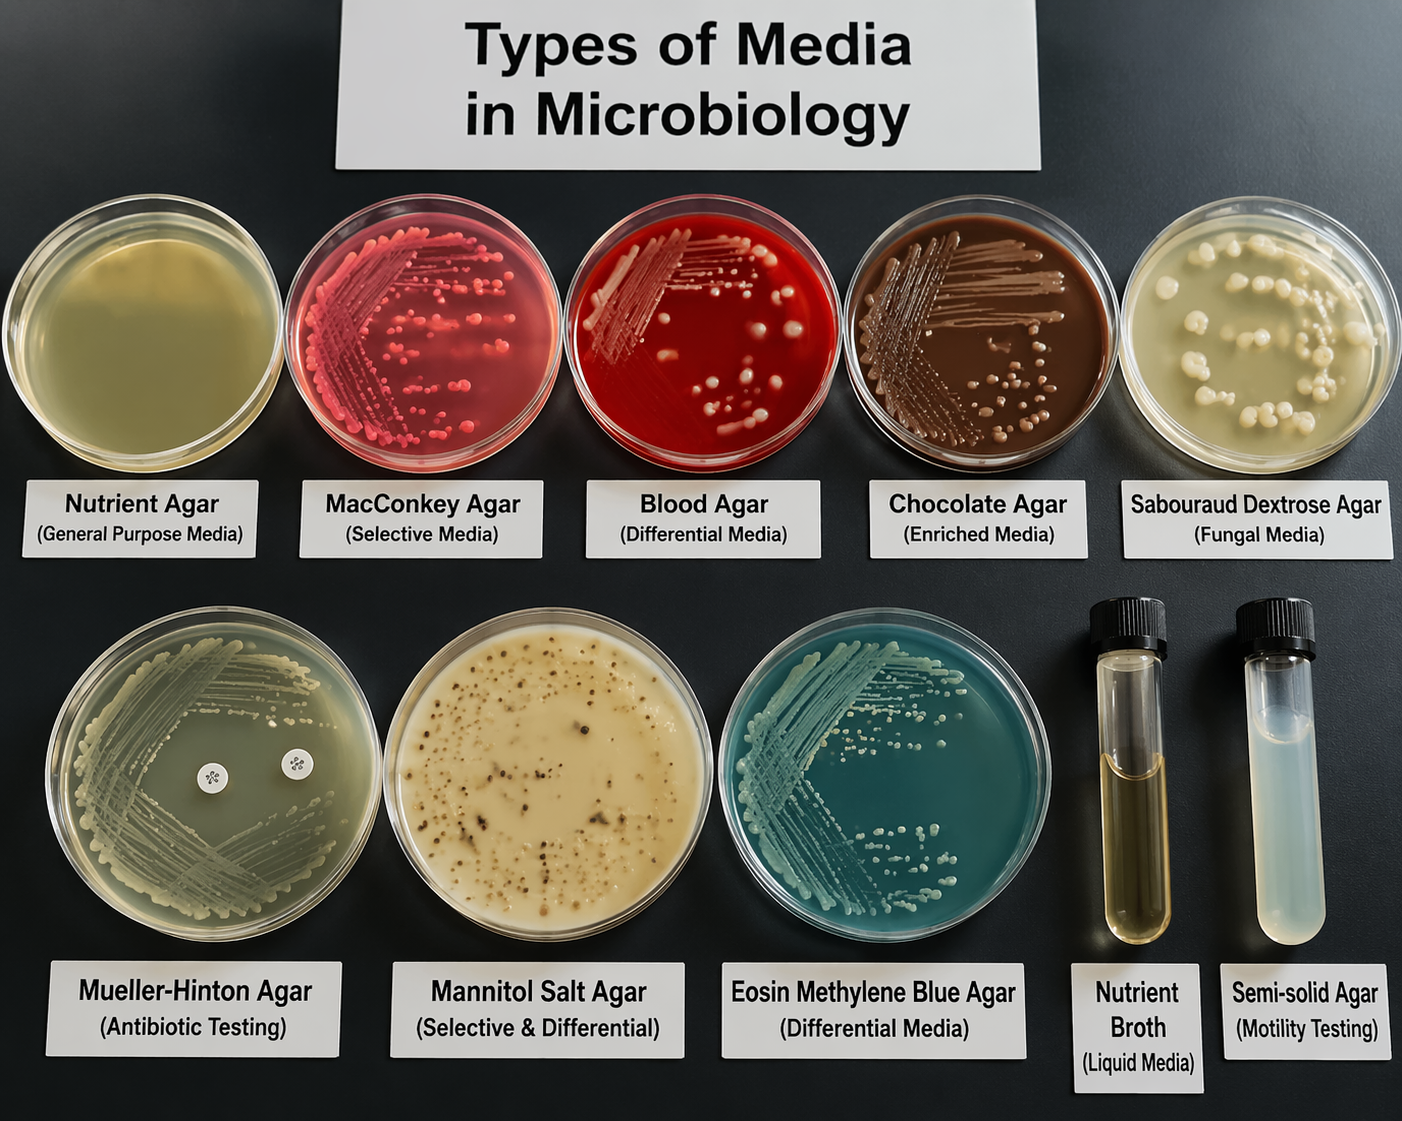

Types of Media in Microbiology
Types of Media in Microbiology: Complete Guide for Laboratory Use
Introduction to Types of Media in Microbiology
Understanding the types of media in microbiology is essential for cultivating, isolating, and studying microorganisms in laboratory settings. Microbiological media provide the nutrients and environmental conditions necessary for microbial growth.
The different types of media in microbiology are designed to support specific organisms or to differentiate between microbial species, making them indispensable in research, diagnostics, and industrial microbiology.
What Are Microbiological Media?
Microbiological media are nutrient-rich substances used to grow microorganisms such as bacteria, fungi, and yeast. These media contain essential components like:
- Carbon sources
- Nitrogen sources
- Vitamins and minerals
- Water
- pH buffers
The selection of the correct types of media in microbiology directly affects the success of microbial growth and identification.
Classification of Types of Media in Microbiology
The types of media in microbiology can be classified based on physical state, chemical composition, and functional purpose.
1. Types of Media in Microbiology Based on Physical State
Liquid Media (Broth)
- No solidifying agent
- Used for growing large numbers of bacteria
- Example: Nutrient broth
Solid Media
- Contains agar (solidifying agent)
- Used for isolating colonies
- Example: Nutrient agar
Semi-solid Media
- Low agar concentration
- Used for motility testing
2. Types of Media in Microbiology Based on Chemical Composition
Defined (Synthetic) Media
- Exact chemical composition is known
- Used in research and metabolic studies
Complex Media
- Contains natural extracts (e.g., yeast extract)
- Exact composition is unknown
- Widely used in routine labs
3. Types of Media in Microbiology Based on Function
This is the most important classification of types of media in microbiology for laboratory diagnostics.
General Purpose Media
- Supports a wide range of organisms
- Example: Nutrient agar
Selective Media
- Inhibits growth of some microorganisms while allowing others
- Example: MacConkey agar (selects Gram-negative bacteria)
Differential Media
- Distinguishes organisms based on biochemical reactions
- Example: Blood agar (hemolysis patterns)
Enriched Media
- Contains additional nutrients for fastidious organisms
- Example: Chocolate agar
Transport Media
- Maintains viability of specimens during transport
- Example: Stuart transport medium
Anaerobic Media
- Supports growth of anaerobic bacteria
- Reduces oxygen levels
Common Examples of Microbiological Media
Here are widely used examples of types of media in microbiology:
- Nutrient agar
- MacConkey agar
- Blood agar
- Chocolate agar
- Sabouraud dextrose agar (for fungi)
- Mueller-Hinton agar (antibiotic testing)
Importance of Types of Media in Microbiology
The correct selection of types of media in microbiology is critical for:
- Accurate microbial identification
- Clinical diagnosis of infections
- Antibiotic susceptibility testing
- Food and water safety analysis
- Research and biotechnology applications
Advantages of Using Different Media Types
- Enables selective growth of specific organisms
- Improves diagnostic accuracy
- Supports diverse microbial requirements
- Facilitates isolation of pure cultures
Limitations of Microbiological Media
- Some microorganisms cannot be cultured
- Risk of contamination
- Requires proper sterilization
- Specific media may be costly
How to Choose the Right Media in Microbiology
To select the best types of media in microbiology, consider:
- Type of microorganism
- Purpose (isolation, identification, storage)
- Oxygen requirements
- Nutritional needs
Conclusion
The types of media in microbiology are fundamental tools that enable scientists to grow, isolate, and study microorganisms effectively. From simple nutrient broths to highly selective and differential media, each type plays a critical role in microbiological analysis.
Mastering the different types of media in microbiology is essential for anyone working in laboratories, healthcare, or research environments.
Recent Posts
-
Types of Media in Microbiology
Types of Media in Microbiology: Complete Guide for Laboratory Use Introduction to Types of Media in …6th Apr 2026 -
How Psychological Stress Worsens Skin Inflammation
How Psychological Stress Worsens Skin Inflammation: The Sympathetic–Eosinophil Axis Explained Introd …23rd Mar 2026 -
Genomic DNA Extraction Kit
Genomic DNA Extraction Kit: A Comprehensive Scientific Overview Introduction A genomic DNA extractio …23rd Mar 2026